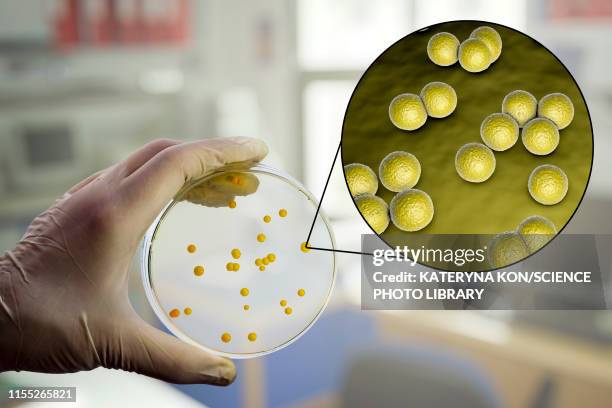
micrococcus luteus bacteria, composite image - micrococcus luteus stock illustrations
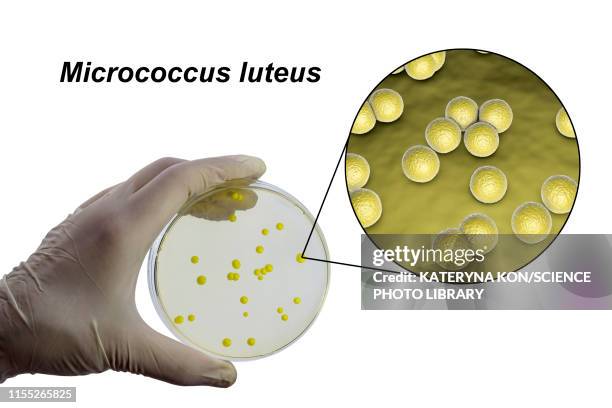
micrococcus luteus bacteria, composite image - micrococcus luteus stock illustrations
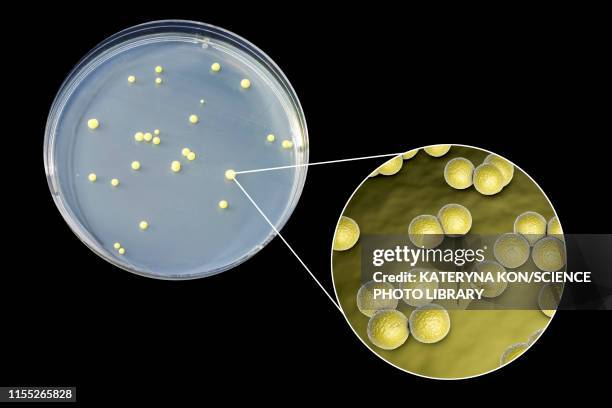
micrococcus luteus bacteria, composite image - micrococcus luteus stock illustrations

19 Micrococcus Luteus Illustrations
View micrococcus luteus videos
Browse 19 high res micrococcus luteus stock illustrations & graphics available royalty-free, or explore staphylococcus epidermidis or helicobacter pylori to find more great images and illustrations.